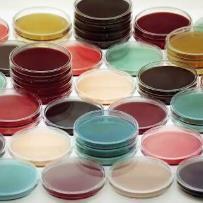
Profile picture

Shymaa Enany
-
Suez Canal UniversityIsmaïlia, Egypt
